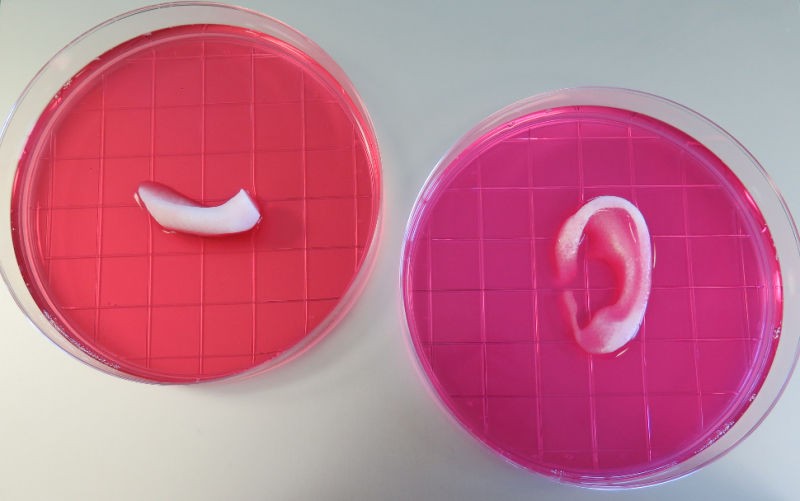
3D εκτυπωτές ανθρώπινων οργάνων

Πόσο μακριά είμαστε από τη στιγμή που ένας τρισδιάστατος εκτυπωτής θα μπορεί να επιδιορθώνει τραυματισμούς, όπως γίνεται σε επιστημονικής φαντασίας ταινίες; Ξαπλώνετε, ένα ρομποτικό χέρι εμφανίζεται και αφού ο γιατρός δώσει μερικές εντολές, αρχίζει να «γεμίζει» την τραυματισμένη σας περιοχή.
Σύμφωνα με τον Μάικ Μέρφι στο Quartz βρισκόμαστε πολύ κοντά στην εποχή που θα τοποθετούμε όργανα στο σώμα μας, όπως βάζουμε και βγάζουμε ένα στικάκι USB.
Ερευνητές από το Wake Forest University, στην Βόρεια Καρολίνα, έχουν κατασκευάσει έναν 3D εκτυπωτή που, ανάμεσα σε άλλα, μπορεί να δημιουργήσει όργανα και κόκαλα. Και, θεωρητικά τουλάχιστον, μπορούν να εμφυτευτούν σε ανθρώπους. Η έρευνά τους δημοσιεύτηκε στο Nature Biotechnology today.
Σύμφωνα με την εργασία τους, ο εκτυπωτής λειτουργεί όπως οι περισσότεροι αντίστοιχοι τριών διαστάσεων. Με απόλυτη ακρίβεια, δημιουργεί το αντικείμενο, τοποθετώντας τα υλικά σε στρώσεις. Στην συνέχεια, οι στρώσεις σκληραίνουν και στο τέλος δημιουργείται αυτό που θέλουμε. Σε αντίθεση όμως με άλλους εκτυπωτές που χρησιμοποιούν λιωμένο πλαστικό ή μέταλλο σε στρώσεις, ο συγκεκριμένος χρησιμοποιεί διάλυμα νερού που περιέχει ανθρώπινα κύτταρα. Ονομάζεται «hydrogel» και μοιάζει με παχύρευστη ουσία. Ο πανεπιστημιακός εκτυπωτής διαθέτει πολλαπλά στόμια για να εξάγει τόσο το «hydrogel» όσο και τα άλλα υλικά που χρειάζονται.
Ετσι, όταν τα υποστηρικτικά υλικά διαλύονται και τελειώσει η επώαση του ιστού στη μηχανή, Θεωρητικά θα μπορούσε αυτός να εμφυτευθεί σε ένα άτομο.

Οι ερευνητές σάρωσαν και στις τρεις διαστάσεις ανθρώπινα αυτιά, σιαγόνες και μυς για να δημιουργήσουν ψηφιακά πρότυπα για τον εκτυπωτή τους. Μετά, εκτύπωσαν ένα κομμάτι αυτιού, ένα κομμάτι σιαγόνας και έναν μυ και τα εμφύτεψαν σε ποντίκια. Η δομή του εκτυπωτή τους, επιτρέπει να εκτυπωθούν ιστοί που μπορούν να φιλοξενήσουν αιμοφόρα αγγεία. Αυτό σημαίνει ότι μπορούν να δεχτούν οξυγόνο και θρεπτικές ουσίες που χρειάζονται τα κύτταρα για να επιβιώσουν. Αυτό ήταν και το μεγαλύτερο πρόβλημα σε πολλούς 3D εκτυπωτές που έχουν προσπαθήσει να κάνουν το ίδιο. Σύμφωνα με την εργασία της ομάδας του πανεπιστημίου, δεν έχουν εμφανιστεί σημάδια νέκρωσης ή κύτταρα που πεθαίνουν μέσα στον εκτυπωμένο ιστό.
Η μελλοντική ανάπτυξη ενός ολοκληρωμένου εκτυπωτή ιστών-οργάνων κατευθύνεται προς την παραγωγή ιστών για εφαρμογές στον άνθρωπο καθώς και στην δημιουργία πιο σύνθετων ιστών και συμπαγών οργάνων, σύμφωνα με όσα είπε ο επικεφαλής ερευνητής της ομάδας, Άντονι Ατάλα, στο Quartz. Ο ίδιος διυκρίνισε: «Κατά την εκτύπωση ανθρώπινων ιστών και οργάνων, φυσικά, θα πρέπει να βεβαιωθούμε ότι τα κύτταρα επιβιώνουν, και ότι λειτουργούν. Αυτή είναι η τελική δοκιμή. Η έρευνά μας, υποδεικνύει ότι μπορούμε να εκτυπώσουμε οστά, μυς, και χόνδρους για τους ασθενείς. Θα χρησιμοποιήσουμε παρόμοια στρατηγική για να εκτυπώσουμε συμπαγή όργανα».
Αξίζει να πούμε ότι οι ερευνητές στο Wake Forest δεν είναι οι μόνοι που χρησιμοποιούν αυτήν την μέθοδο έρευνας. Ο Τοντ Γκολντστάιν, ένας ερευνητής στο Feinstein Institute for Medical Research του οργανισμού Northwell Health, δήλωσε στο Quartz ότι αυτό δεν είναι κάτι νέο. Ο ίδιος αυτό το διάστημα προσπαθεί να εκτυπώσει ανθρώπινα κύτταρα για χρήση σε εμφυτεύσιμες τραχείες. Και πρόσθεσε ότι οι πραγματικές καινοτομίες της έρευνάς του είναι ότι έχει συνδυαστεί όλη η διαδικασία σε ένα μόλις μηχάνημα και έχει επιτευχθεί υψηλή ποιότητα στα αποτελέσματα που έχουν. Για παράδειγμα, όπως είπε, «αν είσαι ένας πραγματικά καλός ζαχαροπλάστης μπορείς να δημιουργήσεις ένα φανταστικό επτά στρώσεων κέικ. Δεν έχεις νέα υλικά αλλά ο τρόπος που θα τα συνδυάσεις θα το κάνει να είναι πολύ νόστιμο».
Πάντως, μια νέα εταιρεία στην Φιλαδέλφεια των ΗΠΑ, η BioBots, πουλάει, για περίπου 10.000 δολάρια, 3D εκτυπωτή που εκτυπώνει ανθρώπινο ιστό.
Και αν τελικά η χρήση 3D εκτυπωτών δεν έχει αποδειχτεί χρήσιμη για τον μέσο καταναλωτή, σε άλλους τομείς μπορεί να αποτελέσει την αιχμή δημιουργίας νέων δυνατοτήτων. Το πρώτο φάρμακο που δημιουργήθηκε από εκτύπωση τριών διαστάσεων εγκρίθηκε για χρήση από τον αντίστοιχο αμερικάνικο οργανισμό φαρμάκων τον περασμένο Αύγουστο. Και γιατροί στην Ισπανία κατάφεραν να τοποθετήσουν με επιτυχία έναν εκτυπωμένο θώρακα από τιτάνιο σε έναν ασθενή τον περασμένο Σεπτέμβριο.
Μένει να δούμε αν τα εκτυπωμένα όργανα θα δοκιμαστούν σε ανθρώπους. Οι ερευνητές αναφέρουν στην εργασία τους ότι η τεχνολογία τους χρειάζεται περαιτέρω ανάπτυξη πριν τα παραγόμενα όργανα δοκιμαστούν σε ανθρώπους
Το λογικό συμπέρασμα της βιοεκτυπωτικής έρευνας, αν τελικά είναι ασφαλής και φερέγγυα, είναι ότι θα μειώσει την αναμονή στις λίστες μεταμοσχεύσεων και ίσως αντικαταστήσει ακόμα και υγιή όργανα με ακόμα καλύτερα, εύχεται ο Μάικ Μέρφι. Εμείς σκεφτόμαστε ότι έτσι θα εξαλειφόταν και η μαύρη αγορά οργάνων καθώς δεν θα είχε νόημα πια.